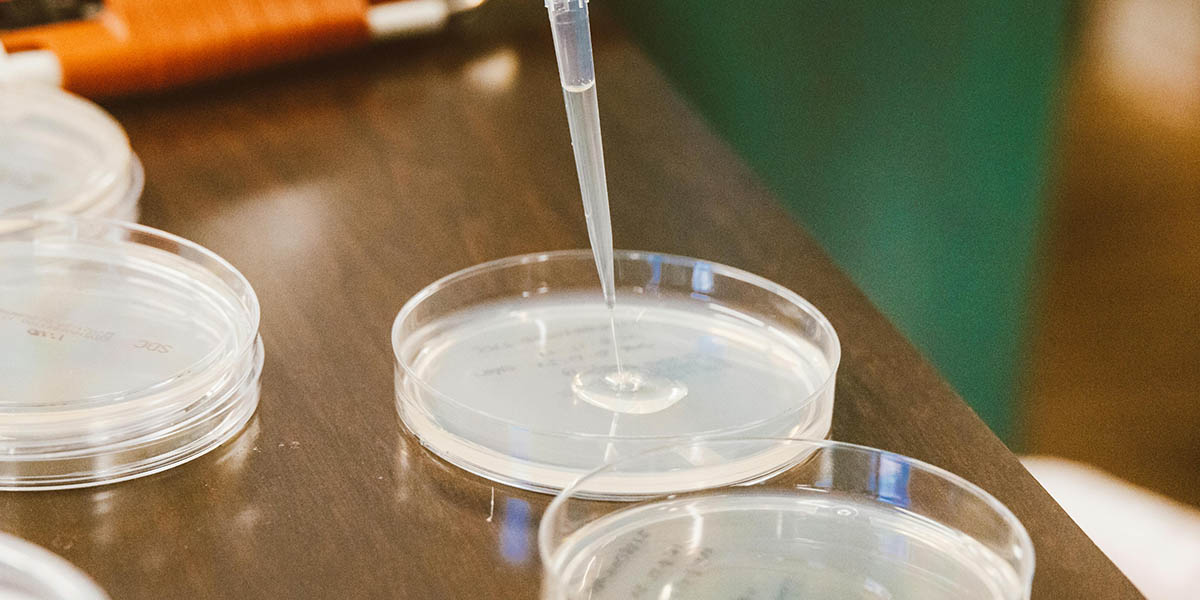

New Binghamton University program to offer project management training in biomanufacturing
$1.6 million project partially supported through BioMADE, a federally sponsored Manufacturing Innovation Institute
Binghamton University has received funding to create a biomanufacturing project management training program to foster leadership skills in students, veterans, entry-level workers and those re-entering the bioindustry workforce.
The $1.6 million workforce training project, announced Wednesday at the White House, is partially supported through BioMADE, a Manufacturing Innovation Institute working to secure America’s future through bioindustrial manufacturing innovation, education and collaboration. The University is also contributing funding.
Leading the effort will be Distinguished Professor and Biomedical Engineering Department Chair Kaiming Ye from the Thomas J. Watson College of Engineering and Applied Science and Professor Shelley Dionne, dean of the School of Management. Also involved in establishing the program are BME Professor Sha Jin; Osterhout Associate Professor of Entrepreneurship Chou-Yu “Joey” Tsai; Director of the Office of Strategic Research Initiatives Michael Jacobson; and Ben Fay, grant and contract administrator for the Office of Sponsored Programs.
Binghamton University is partnering with the National Corn-to-Ethanol Research Center (NCERC) at Southern Illinois University - Edwardsville for this project, as well as representatives from industry.
“This project is a tremendous combination of several factors crucial to Binghamton University’s mission: workforce and economic development, technology and sustainability,” said President Harvey Stenger. “There is a great demand for leadership and skill in the biomanufacturing workforce, and I’m proud to see Binghamton taking a significant role in this space. I’m also excited about the partnerships with industry, which will have long-term benefits for our faculty and students as well as the entire biomanufacturing economy.”
“My congratulations to the faculty in Watson College and the School of Management for partnering on such a unique and innovative project that is going to prepare students for careers in biomanufacturing,” said Donald Hall, provost and executive vice president for Academic Affairs. “Career preparation, internships and hands-on experiences are crucial components of learning for today’s students, and I am also encouraged by the networking opportunities with industry partners that will benefit Binghamton students and faculty alike.”
BioMADE Associate Program Manager Hunter Brown added: “This project offers a promising model of blended online content and intensive hands-on, pilot-scale training to expand career pipeline access at capacities necessary to address critical unmet needs in the U.S. bioindustrial manufacturing workforce.”
Dionne said she and Tsai are excited to partner with Watson College colleagues to provide customized technical and leadership training to enhance the biomanufacturing workforce: “The foundational skills that participants develop in our program have the potential to transform workforce development in various regions throughout the U.S.”
Tsai added: “Our interdisciplinary collaboration will result in a redesigned project management training that will significantly accelerate and benefit the development of the biomanufacturing workforce.”
“This program is an incredible opportunity to put Binghamton University at the forefront of the bioindustrial manufacturing industry,” Watson College Dean Atul Kelkar said. “By training future leaders, we will foster solutions to improve biotechnology and other key economic sectors.”
The program hopes to enroll 25 to 30 students in its first cohort for a six-month course of specialized online training modules focused on environmentally friendly biomanufacturing using “green” chemistry.
“This new training paradigm will grow the essential workforce for biomanufacturing by removing the many barriers facing workers, particularly those from underrepresented groups who pursue these careers,” Ye said.
Core courses will cover the fundamentals of project management and leadership skills in a digital world, and electives will include data science, product management, creative thinking and innovation implementation. The curriculum will put a special focus on how artificial intelligence and machine learning can innovate the biomanufacturing process from the supply chain down to the product release to users.
Also included will be a week-long onsite training at NCERC, a capstone project that tackles a real-world problem, and internship opportunities with industry collaborators.
BioMADE funding supports the first two years of program development, but within five years, organizers hope to enroll 100 or more students per session through a national training program with four U.S. nodes on the East and West Coasts, the Southeast and Midwest.

